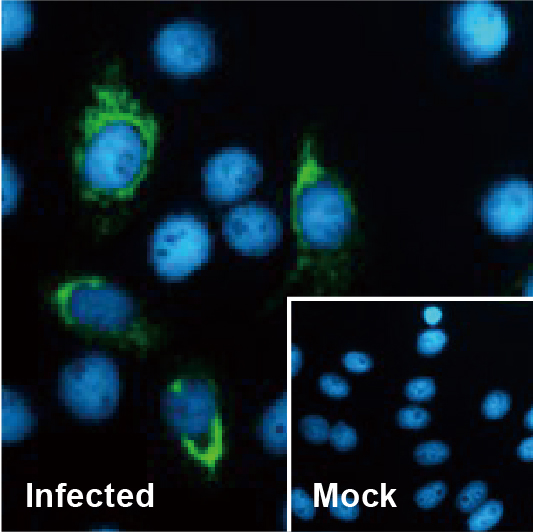
新闻图片10

公司新闻/正文
802 人阅读发布时间:2024-04-24 17:30

黄病毒是正义RNA病毒,通常通过节肢动物传播,可导致人类严重疾病。病毒感染导致内质网膜重塑、复制细胞器形成和细胞骨架重组,这些都是病毒复制的重要过程,细胞骨架和核骨架通过内核膜上的SUN蛋白和外核膜上的Nesprins连接,并且已知SUN蛋白对于HIV-1和单纯疱疹病毒感染很重要。然而,人们对它们在细胞质复制RNA病毒生命周期中的作用知之甚少。
黄等人最近的一项研究试图探索两种广泛表达的SUN蛋白SUN1和SUN2在黄病毒感染中的功能(1)。研究人员发现,CRISPR/Cas9介导的SUN2敲除(而非SUN1)减少了包括登革热病毒、寨卡病毒和日本脑炎病毒在内的多种黄病毒的复制,而对其他非黄病毒科RNA病毒没有影响,SUN2的缺失分析表明,全长蛋白是促进寨卡病毒复制所必需的,一系列机制实验表明,SUN2对于内质网膜重塑、复制细胞器形成和细胞骨架重组至关重要。研究小组随后透露,SUN2对于寨卡病毒NS1和肌动蛋白之间通过Nesprin-1和-2的相互作用至关重要。有趣的是,感染寨卡病毒的SUN2基因敲除小鼠比野生型小鼠表现出更长的生存时间、更少的麻痹和小头畸形,并且病毒载量低2-3个对数。黄等人的这份研究,提出了影响黄病毒感染的关键细胞因素的新视角,并为潜在的抗病毒干预提供了新的治疗靶点。
GeneTex 为病毒传染病,特别是黄病毒研究提供广泛的优质抗体和试剂目录,包括 Zika virus Envelope protein antibody [GT363] (GTX634155)和Huang 等人在研究中引用的其他五种被广泛引用的寨卡病毒蛋白多克隆抗体。此外,GeneTex要介紹其经过嚴格验证的重组兔单克隆Zika virus Envelope protein antibody [HL1699] (GTX637298)以及其他针对寨卡病毒NS1、NS2B、NS4B和NS5的新型重组单克隆抗体。欲了解更多信息,请参阅下面的产品图片并访问www.genetex.com。
热门研究产品



Zika virus Envelope protein antibody [HL1699] (GTX637298) 

Zika virus NS1 protein antibody [HL2567] (GTX638945) 

Zika virus NS2B protein antibody [HL2151] (GTX638129)
Zika virus NS4B protein antibody [HL1663] (GTX637261) 

Zika virus NS5 protein antibody [HL2154] (GTX638132)

精选产品
| 目录号 | 产品名 | 应用 | |
| GTX133317 |
Zika virus Capsid protein antibody |
WB, ICC/IF, IHC-P (cell pellet) | ![]() |
| GTX133305 |
Zika virus prM protein antibody |
WB, ICC/IF, IP |
|
| GTX133314 | Zika virus Envelope protein antibody | WB, ICC/IF, IHC-P | ![]() |
| GTX133325 | Zika virus Envelope protein antibody | WB, ICC/IF, ELISA, Sandwich ELISA | ![]() |
| GTX634155 |
Zika virus Envelope protein antibody [GT363] |
WB, ICC/IF, ELISA, IHC, Sandwich ELISA | ![]() |
| GTX637298 | Zika virus Envelope protein antibody [HL1699] | WB, ICC/IF |
|
| GTX133307 | Zika virus NS1 protein antibody | WB, ICC/IF, ELISA, Sandwich ELISA | ![]() |
| GTX634159 |
Zika virus NS1 protein antibody [GT281] |
WB, ICC/IF, IHC-P | ![]() |
| GTX634158 |
Zika virus NS1 protein antibody [GT5212] |
WB, ICC/IF, ELISA, Sandwich ELISA | ![]() |
| GTX638945 |
Zika virus NS1 protein antibody [HL2567] |
WB | ![]() |
| GTX133308 |
Zika virus NS2B protein antibody |
WB, ICC/IF, IHC-P, IHC-Fr, IHC-P (cell pellet) |
![]() |
| GTX638129 |
Zika virus NS2B protein antibody [HL2151] |
WB, ICC/IF | ![]() |
| GTX133309 |
Zika virus NS3 protein antibody |
WB, ICC/IF, IHC-P | ![]() |
| GTX133704 | Zika virus NS4A protein antibody | WB, ICC/IF | ![]() |
| GTX133311 |
Zika virus NS4B protein antibody |
WB, ICC/IF, IHC-Fr, FACS | ![]() |
| GTX133321 |
Zika virus NS4B protein antibody |
WB, ICC/IF, IHC-P (cell pellet) |
![]() |
| GTX637261 |
Zika virus NS4B protein antibody [HL1663] |
WB, ICC/IF, IHC-P (cell pellet) |
|
| GTX133312 |
Zika virus NS5 protein antibody |
WB, ICC/IF | ![]() |
| GTX133327 |
Zika virus NS5 protein antibody |
WB, ICC/IF, IP | ![]() |
| GTX638132 |
Zika virus NS5 protein antibody [HL2154] |
WB, ICC/IF |
|
![]() |
黄病毒研究挂图
![]() |